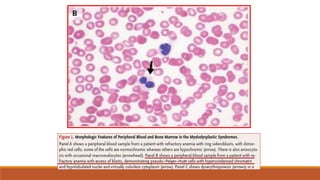
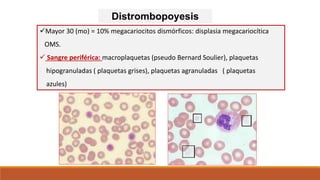
Distrombopoyesis
Mayor 30 (mo) = 10% megacariocitos dismórficos: displasia megacariocítica
OMS.
 Sangre periférica: macroplaquetas (pseudo Bernard Soulier), plaquetas
hipogranuladas ( plaquetas grises), plaquetas agranuladas ( plaquetas
azules)

Los síndromes mielodisplásicos (SMD) son un conjunto de enfermedades clonales de las células progenitoras hematopoyéticas caracterizadas por hematopoyesis ineficaz, presencia de citopenias, y alteraciones morfológicas celulares. Representan un complejo grupo de neoplasias hematológicas que comparten como características comunes la presencia de citopenias y una tendencia a evolucionar a leucemia mieloblástica aguda. La clasificación de los SMD se revisó en 2008 por la Organización M